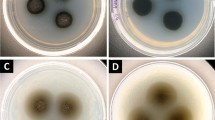

Abstract
Botryococcus braunii (Chlorophyta, Botryococcaceae) is a colony-forming green microalga that produces large amounts of liquid hydrocarbons, which can be converted into transportation fuels. There are three different races of B. braunii, A, B, and L, that are distinguished based on the type of hydrocarbon each produces. Each race also has many strains that are distinguished by the location from which they were collected. While B. braunii has been well studied for the chemistry of the hydrocarbon production, very little is known about the molecular biology of B. braunii. To begin to address this problem, we determined the genome size of the A race, Yamanaka strain, and the L race, Songkla Nakarin strain, of B. braunii. Flow cytometry analysis indicates that the A race of B. braunii has a genome size of 166.0 ± 0.4 Mb, while the L race has a substantially larger genome size at 211.3 ± 1.7 Mb. We also used phylogenetic analysis with the nuclear small subunit (18S) rRNA gene to classify strains of the A and B races that have not yet been compared evolutionarily to previously published B. braunii phylogenetics. The analysis suggests that the evolutionary relationship between B. braunii races is correlated with the type of liquid hydrocarbon they produce.
Similar content being viewed by others
Avoid common mistakes on your manuscript.
Introduction
Genome sizes of organisms have become an increasingly important biological parameter with the onset of genome sequencing projects. They are also beneficial to almost all levels of biological sciences including evolution, ecology, phylogenetics, and molecular biology (Bennett et al. 2000; Bennett and Leitch 2005; Doležel and Bartos 2005). While a large number of genome size estimates are now available for photosynthetic organisms (∼6,000 reported genome sizes, http://data.kew.org/cvalues/; Bennett and Leitch 2005), of the estimated 200,000 algae species (Chapman 2005), only about 300 algae have had genome sizes determined (Kapraun 2005, 2007). Over half of these are green algae. In recent years, interest has been renewed in using green algae as source of biofuels for transportation needs, and an improved understanding of algal molecular biology will be required if green algae are to become a viable source of biofuels (Chisti 2007, 2008). Determination of genome sizes and phylogenetic relationships for more green algae will help to lay the foundation for understanding cellular processes of these organisms at the molecular level, which is sorely lacking.
Botryococcus braunii is a green colonial microalga with the cells of the colony held together by an extracellular matrix composed of a cross-linked aldehyde polymer core (Maxwell et al. 1968; Knights et al. 1970; Metzger et al. 1993, 2008). Botryococcus braunii is well known for its ability to produce large amounts of liquid hydrocarbons, which are largely stored in the extracellular matrix. These hydrocarbons can be processed into petroleum-equivalent products for use in combustion engines (Banerjee et al. 2002). These characteristics have made B. braunii attractive as a potential source of renewable fuel.
Botryococcus braunii species are divided into three races (A, B, and L), which are classified based on the chemical nature of the liquid hydrocarbons produced. Alkadienes and alkatrienes derived from fatty acids are produced in the A race (Templier et al. 1984, 1991; Metzger et al. 1985a, 1986), the isoprenoid-derived triterpenes known as botryococcenes are produced in the B race (Metzger et al. 1985a, b, 1987, 1988), and the isoprenoid-derived tetraterpene known as lycopadiene is produced in the L race (Metzger and Casadevall 1987; Metzger et al. 1990). Interestingly, B. braunii hydrocarbon oils from all three races have been identified as major components of currently used petroleum and coal deposits (Traverse 1955; Cane 1977; Moldowan and Seifert 1980; Brassel et al. 1986; McKirdy et al. 1986; Glikson et al. 1989; Mastalerz and Hower 1996; Stasiuk 1999; Testa et al. 2001; Audino et al. 2002; Summons et al. 2002; Adam et al. 2006).
In an effort to initiate a better molecular-level comprehension of B. braunii, we previously used a well-established flow cytometry protocol (Johnston et al. 2004, 2005, 2007) to determine the genome size of the B race of B. braunii, Berkeley strain (166.2 ± 2.2 Mb; Weiss et al. 2010). Here, we have applied the same protocol to the A race, Yamanaka strain, and the L race, Songkla Nakarin strain, of B. braunii to determine their genome sizes. We have also phylogenetically placed several new strains of the B race and one A race using 18S rRNA gene sequences.
Materials and methods
Details on the isolation of the Yamanaka strain of B. braunii, A race, the Kawaguchi-1 and -2 and the Yayoi strains, B race, have been previously reported (Okada et al. 1995). The Songkla Nakarin strain of B. braunii, L race (Metzger and Casadevall 1987; Metzger et al. 1990), was obtained from the Algobank-Caen Microalgal Culture Collection, University of Caen Basse-Normandie, France.
All algal cultures were illuminated using 13-W compact fluorescent 65-K lighting at a distance of 7.62 cm, which produced a light intensity of 280 μmol photons m−2 s−1. Lighting was on a 12-h light/12-h dark cycle at 22.5°C. The cultures were continuously aerated with filter-sterilized, enriched air containing 2.5% CO2. Fifty mL of culture was used to inoculate 750 mL of subsequent subcultures every 4 weeks. The cultures were grown in modified Chu 13 medium (Grung et al. 1989).
Algal protoplast production and nuclei isolation
B. braunii nuclei were isolated as previously described (Weiss et al. 2010). Basically, 50 mg of frozen algal cells was resuspended in 500 μL of cold Galbraith buffer (Galbraith et al. 1983), and protoplasts were generated using 1 mg of lyticase (Jazwinski 1990) (Sigma, USA). The sample was then spread across a glass slide, thoroughly chopped through with a new razor blade, and incubated at room temperature for 30 min; the sample was combined with the head from a female wild-type strain of Drosophila virilis, which served as a standard (333.3 Mb) (Gregory and Johnston 2008); nuclei were liberated using a Kontes 2-mL Dounce tissue grinder; the mixture was filtered with a 50-μm filter and stained with 50 ppm propidium iodide (Sigma, USA) for 30 min at 4°C in the dark.
Flow cytometry for genome size estimation
Flow cytometry on isolated nuclei was carried out using a Beckman FACScan flow cytometer as previously described (Weiss et al. 2010). To ensure that scoring included only intact nuclei free from cytoplasmic tags, counting was activated by red fluorescence, and only nuclei with low forward and low side scatter were included in the analysis. Samples were run to produce a total of at least 1,000 nuclei under each scored peak. DNA content was determined from co-preparations of sample and standard by multiplying the ratio of the mean peak fluorescence of the diploid (2C) sample to the 2C mean fluorescent peak of D. virilis times the genome size of the standard (1C = 333.3 Mb for D. virilis) (Gregory and Johnston 2008). A total of three genome size estimations for each alga were carried out over a 3-week period, and a 1C average and standard error were calculated based on the produced genome sizes.
rDNA amplification
The B. braunii 18S rRNA genes were amplified by polymerase chain reaction (PCR) from genomic DNA that was extracted with Nucleon Phytopure (GE Healthcare UK Ltd.) according to the manufacture’s protocol. The genomic DNA was then used as a template to amplify the nuclear 18S rRNA gene by PCR in two overlapping sections using the same combinations of primers used by Sawayama et al. (1995); primer combination 1, 5′-TACCTGGTTGATCCTGCCAGTAG and 5′-CCAATCCCTAGTCGGCATCGT, and primer combination 2, 5′-AGATACCGTCGTAGTCTCAACCA and 5′-ACCTTGTTACGACTTCTCCTTCCTC. PCR was carried out with 1.25 units of Takara EX Taq polymerase (Takara Bio Inc., Japan) in the supplied 1× PCR buffer, 0.4 mM dNTPs, 2 μM of each primer, and 1 μL (10 ng) of genomic DNA in a final volume of 50 μL. PCR cycles were as follows: one cycle with initial incubation at 98°C for 10 s, annealing at 62°C for primer combination 1 or 59°C for primer combination 2 for 1 min, extension at 72°C for 2 min, followed by 34 cycles of 94°C for 20 s, 62°C (for primer combination 1) or 59°C (for primer combination 2) for 1 min, 72°C for 2 min, and a final incubation at 72°C for 5 min. PCR products were isolated from agarose gels using MagExtractor (Toyobo Co. Ltd., Japan), blunt-ligated into the EcoRV site of pBluescript II KS + (Stratagene, USA), transformed into Escherichia coli XL-1 Blue MRF’ strain (Stratagene) according to a standard CaCl2 transformation procedure, and sequenced on both strands by the dideoxy terminator method using a Thermo Sequenase Primer Cycle Sequencing kit (GE Healthcare, USA) in a Shimadzu DQ2000 DNA sequencer (Shimadzu, Japan). The isolated B. braunii 18S rDNA sequences reported here were deposited in GenBank: B race strains Yayoi (accession HM245351), Kawaguchi 1 (accession HM245349), and Kawaguchi 2 (accession HM245350) and A race strain Yamanaka (accession HM245352).
Phylogenetic analysis
The 18S rRNA gene sequences used for phylogenetic analysis were those produced here plus 34 obtained from GenBank based on accession numbers given in Senousy et al. (2004) and Weiss et al. (2010). The final 18S rRNA alignment used by Senousy et al. (2004) for phylogenetic analysis was obtained from TreeBASE (http://www.trebase.org/treebase/); a new alignment including the newly isolated 18S rRNA sequences described here was produced using MEGA 4.1 (Tamura et al. 2007).
Trees were constructed using MEGA 4.1 (Tamura et al. 2007), MrBayes (Hall 2001; Huelsenbeck and Ronquist 2001), and PhyMl 3.0 (Guindon and Gascuel 2003) as previously described (Weiss et al. 2010). Trees were drawn with MEGA 4.1 (Tamura et al. 2007) and TreeView (Page 1996). Data analysis methods included distance (neighbor-joining and minimum evolution), maximum parsimony, and likelihood (maximum likelihood and Bayesian inference). All bootstrap analyses were carried out with at least 500 replications each. All remaining parameters were the same or equivalent to those found in Weiss et al. (2010). The B. braunii rRNA alignments have been submitted to TreeBASE (http://www.treebase.org/treebase/), study accession no. S10552.
Results and discussion
Genome size determination of B. braunii, A race Yamanaka strain and L race Songkla Nakarin strain
Using the Berkeley strain of the B. braunii B race, we previously determined that flow cytometry was suitable for genome size determination on B. braunii (Weiss et al. 2010). We used this same flow cytometry method to estimate the genome sizes for the A and L races of B. braunii. We found that the Yamanaka strain of the A race has a genome size of 166.0 ± 0.4 Mb (mean ± SE; n = 2; Fig. 1b). This translates to a 1C DNA content of 0.17 pg, based on 1 pg of DNA = 978 Mb (Doležel et al. 2003). The Songkla Nakarin strain of the L race has a genome size of 211.3 ± 1.7 Mb (mean ± SE; n = 5: Fig. 1c), which is equal to a 0.22 pg 1C DNA content.
Flow cytometry analysis of B. braunii A and L races for genome size determination. Diagrams show the number of nuclei with differing levels of red fluorescence from propidium iodide binding to DNA of a 2C and 4C nuclei of D. virilis, b 2C nuclei of B. braunii, A race, Yamanaka strain and 2C and 4C nuclei of D. virilis, and c 2C nuclei of B. braunii, L race, Songkla Nakarin strain and 2C and 4C nuclei of D. virilis
This A race genome size is nearly identical to that of the B race (166.2 ± 2.2 Mb; Weiss et al. 2010). However, the L race genome size is substantially larger than the B and A races. The significance to this difference between the L race and the B and A races in terms of how these races diverged is not clear at this time. However, in many organisms such as flax, Arabidopsis, head lice, and Drosophila, there are significant differences in genome sizes between different strains of the same species, and these differences can be used to draw evolutionary relationships (Cullis 2005; Bosco et al. 2007; Davison et al. 2007; Johnston et al. 2007; Biemont 2008; Gregory and Johnston 2008). Unfortunately, there is not enough information on B. braunii genome sizes to allow such evolutionary comparisons. This will require a wider sampling of genome sizes for the different strains within each race of B. braunii. Since our genome size analysis included only one representative from each race of B. braunii, additional genome size determinations may also indicate that other strains of the A and B race have genomes of similar size to the L race. Therefore, the differences between the races shown here should be considered with caution before further analysis can be carried out.
While genome sizes of green algae vary greatly (9.8–1,040 Mb; Kapraun 2005, 2007), the size of the B. braunii genomes shown here and in our previous studies (Weiss et al. 2010) are larger than those of all sequenced algal genomes. The closest genome sizes to B. braunii are that of Chlamydomonas reinhardtii at 120 Mb (Merchant et al. 2007) and Volvox carteri at 138 Mb (Prochnik et al. 2010). This makes it interesting to speculate about the reasons for the increased B. braunii genome size in comparison to these sequenced algal genomes. One possibility is gene number, which ranges from ∼5,300 in the 16.5-Mb genome of Cyanidioschyzon merolae (Matsuzaki et al. 2004) to ∼14,500 in the 120- and 138-Mb genomes of V. carteri and C. reinhardtii, respectively. Thus, there appears to be a general correlation between genome size and gene number, and B. braunii may have a larger number of genes. Another possibility for the increased genome size of B. braunii as compared to other sequenced algae is a phenomenon we have noticed when cloning genes from B. braunii; its genes have a 3′ untranslated region (UTR) much larger than that of genes from other organisms. For example, the 3′ UTR of squalene synthase from B. braunii is 1,009 bp (Okada et al. 2000) while the 3′ UTR of tobacco (Devarenne et al. 1998) and Arabidopsis (Kribii et al. 1997) squalene synthase is 279 and 261 bp, respectively. In any case, full genome sequencing will reveal the true nature of the content of the B. braunii genome.
Phylogenetic placement of the B. braunii races
In order to widen the view of the phylogenetic relationships between the different races and strains of B. braunii, we have isolated the 18S rDNA sequences from three additional strains of the B race (Yayoi, Kawaguchi-1, and Kawaguchi-2; Okada et al. 1995) and one strain of the A race (Yamanaka; Okada et al. 1995). Our current phylogenetic analysis followed that of Weiss et al. (2010). Initially, the new B. braunii 18S rDNA sequences were analyzed in comparison to the 24 chlorophycean and 26 trebouxiophycean species in Weiss et al. (2010) and showed that these new B. braunii sequences are placed in the class Trebouxiophyceae (not shown). This is in agreement with previous studies that show all races of B. braunii belong to Trebouxiophyceae (Senousy et al. 2004; Weiss et al. 2010). Next, we focused the phylogenetic analysis on the distribution of B. braunii within Trebouxiophyceae. The phylogenetic tree based on the Bayesian inference method is shown in Fig. 2 with bootstrap values from Bayesian inference, maximum likelihood, and maximum parsimony shown. Previous phylogenetic analysis has shown that B. braunii forms a monophyletic group in Trebouxiophyceae with two lineages: one containing the A race and one containing the B and L races (Sawayama et al. 1995; Senousy et al. 2004; Weiss et al. 2010). Including the new B. braunii 18S rDNA sequences strengthens this clustering by showing that the Yamanaka strain of the A race clusters with the Titicaca strain of the A race (Fig. 2). The Kawaguchi strains of the B race cluster together, while the Yayoi strain of the B race clusters with the Ayamé strain of the B race (Fig. 2).
Bayesian inference phylogenetic tree of 18S rRNA sequences. Sequences are identified by their corresponding GenBank, DDJB, or EMBL accession numbers and organism name. Branching credibility percentages from the Bayesian inference (left), maximum likelihood method (middle), and bootstrap maximum parsimony (right) are listed. Where differential branching from the Bayesian inference method occurs, confidence values for the dissenting method is represented by a dash. The focuses of this study, B. braunii, B race strains Yayoi (HM245351), Kawaguchi-1 (HM245349) and Kawaguchi-2 (HM245350), and A race strain Yamanaka (HM245352) are shown in bold. The scale bar is for 0.1 substitutions per site
Interestingly, the B race and L race of B. braunii are found within the same lineage of our phylogenetic analysis, suggesting a close evolutionary relationship. It has been suggested this relationship relates to the commonality of an isoprenoid-based hydrocarbon produced by these races (Senousy et al. 2004; Weiss et al. 2010). However, their genome sizes are significantly different (Fig. 1b, c), which questions this close phylogenetic relationship. It is also questioned by the finding that the chemical composition of the A and B race cell walls are very similar, while the L race has a distinctly different cell wall chemical composition (Derenne et al. 1989; Behar et al. 1995). The B and L race phylogenetic relationship can be clarified in the future by obtaining 18S rDNA sequences from additional L race strains for phylogenetic analysis as well as a wider analysis of genome sizes for the different races and strains of B. braunii.
These and our previous studies (Weiss et al. 2010) have begun to lay the foundation for increasing our knowledge about B. braunii molecular biology and determining the evolutionary relationships between and among the B. braunii races. More in-depth analysis of this kind will be invaluable in moving B. braunii forward as a feasible alga for biofuel production.
References
Adam P, Schaeffer P, Albrecht P (2006) C40 monoaromatic lycopane derivatives as indicators of the contribution of the alga Botryococcus braunii race L to the organic matter of Messel oil shale (Eocene, Germany). Org Geochem 37:584–596
Audino M, Grice K, Alexander R, Kagi RI (2002) Macrocyclic alkanes in crude oils from the algaenan of Botryococcus braunii. Org Geochem 33:979–984
Banerjee A, Sharma R, Chisti Y, Banerjee UC (2002) Botryococcus braunii: a renewable source of hydrocarbons and other chemicals. Crit Rev Biotechnol 22:245–279
Behar F, Derenne S, Largeau C (1995) Closed pyrolyses of the isoprenoid algaenan of Botryococcus braunii, L race: geochemical implications for derived kerogens. Geochim Cosmochim Acta 59:2983–2997
Bennett MD, Leitch IJ (2005) Nuclear DNA amounts in angiosperms: progress, problems and prospects. Ann Bot 95:45–90
Bennett MD, Bhandol P, Leitch IJ (2000) Nuclear DNA amounts in angiosperms and their modern uses—807 new estimates. Ann Bot 86:859–909
Biemont C (2008) Genome size evolution: within-species variation in genome size. Heredity 101:297–298
Bosco G, Campbell P, Leiva-Neto JT, Markow TA (2007) Analysis of Drosophila species genome size and satellite DNA content reveals significant differences among strains as well as between species. Genetics 177:1277–1290
Brassel SC, Eglinton G, Mo FJ (1986) Biological marker compounds as indicator of the depositional history of the Maoming oil shale. Org Geochem 10:927–941
Cane RF (1977) Coorongite, balkashite and related substances—an annotated bibliography. Trans R Soc S Aust 101:153–154
Chapman AD (2005) Numbers of living species in Australia and the world. Report for the Department of the Environment and Heritage, pp 1–64
Chisti Y (2007) Biodiesel from microalgae. Biotechnol Adv 25:294–306
Chisti Y (2008) Biodiesel from microalgae beats bioethanol. Trends Biotechnol 26:126–131
Cullis CA (2005) Mechanisms and control of rapid genomic changes in flax. Ann Bot (Lond) 95:201–206
Davison J, Tyagi A, Comai L (2007) Large-scale polymorphism of heterochromatic repeats in the DNA of Arabidopsis thaliana. BMC Plant Biol 7:44. doi:10.1186/1471-2229-7-44
Derenne S, Largeau C, Casadevall E, Berkaloff C (1989) Occurrence of a resistant biopolymer in the L race of Botryococcus braunii. Phytochemistry 28:1137–1142
Devarenne TP, Shin DH, Back K, Yin S, Chappell J (1998) Molecular characterization of tobacco squalene synthase and regulation in response to fungal elicitor. Arch Biochem Biophys 349:205–215
Doležel J, Bartos J (2005) Plant DNA flow cytometry and estimation of nuclear genome size. Ann Bot (Lond) 95:99–110
Doležel J, Bartos J, Voglmayr H, Greilhuber J (2003) Nuclear DNA content and genome size of trout and human. Cytom A 51:127–128, author reply 129
Galbraith DW, Harkins KR, Maddox JM, Ayres NM, Sharma DP, Firoozabady E (1983) Rapid flow cytometric analysis of the cell cycle in intact plant tissues. Science 220:1049–1051
Glikson M, Lindsay K, Saxby J (1989) Botryococcus—A planktonic green alga, the source of petroleum through the ages: transmission electron microscopical studies of oil shales and petroleum source rocks. Org Geochem 14:595–608
Gregory TR, Johnston JS (2008) Genome size diversity in the family Drosophilidae. Heredity 101:228–238
Grung M, Metzger P, Liaaen-Jensen S (1989) Primary and secondary carotenoids in two races of the green alga Botryococcus braunii. Biochem Syst Ecol 17:263–269
Guindon S, Gascuel O (2003) A simple, fast, and accurate algorithm to estimate large phylogenies by maximum likelihood. Syst Biol 52:696–704
Hall BG (2001) Phylogenetic trees made easy: a how-to manual for molecular biologists. Sinauer, Sunderland
Huelsenbeck JP, Ronquist F (2001) MRBAYES: Bayesian inference of phylogenetic trees. Bioinformatics 17:754–755
Jazwinski SM (1990) Preparation of extracts from yeast. Methods Enzymol 182:154–174
Johnston JS, Ross LD, Beani L, Hughes DP, Kathirithamby J (2004) Tiny genomes and endoreduplication in Strepsiptera. Insect Mol Biol 13:581–585
Johnston JS, Pepper AE, Hall AE, Chen ZJ, Hodnett G, Drabek J, Lopez R, Price HJ (2005) Evolution of genome size in Brassicaceae. Ann Bot 95:229–235
Johnston JS, Yoon KS, Strycharz JP, Pittendrigh BR, Clark JM (2007) Body lice and head lice (Anoplura: Pediculidae) have the smallest genomes of any hemimetabolous insect reported to date. J Med Entomol 44:1009–1012
Kapraun DF (2005) Nuclear DNA content estimates in multicellular green, red and brown algae: phylogenetic considerations. Ann Bot 95:7–44
Kapraun DF (2007) Nuclear DNA content estimates in green algal lineages: Chlorophyta and Streptophyta. Ann Bot 99:677–701
Knights BA, Brown AC, Conway E, Middleditch BS (1970) Hydrocarbons from the green form of the freshwater alga Botryococcus braunii. Phytochemistry 9:1317–1324
Kribii R, Arro M, Del Arco A, Gonzalez V, Balcells L, Delourme D, Ferrer A, Karst F, Boronat A (1997) Cloning and characterization of the Arabidopsis thaliana SQS1 gene encoding squalene synthase—involvement of the C-terminal region of the enzyme in the channeling of squalene through the sterol pathway. Eur J Biochem 249:61–69
Mastalerz M, Hower JC (1996) Elemental composition and molecular structure of Botryococcus alginite in Westphalian cannel coals from Kentucky. Org Geochem 24:301–308
Matsuzaki M, Misumi O, Shin IT, Maruyama S, Takahara M, Miyagishima et al (2004) Genome sequence of the ultrasmall unicellular red alga Cyanidioschyzon merolae 10D. Nature 428:653–657
Maxwell JR, Douglas AG, Eglinton G, McCornick A (1968) Botryococcenes-hydrocarbons of novel structure from the alga Botryococcus braunii Kutzing. Phytochemistry 7:2157–2171
McKirdy DM, Cox RE, Volkman JK, Howell VJ (1986) Botryococcanes in a new class of Australian on-marine crude oils. Nature 320:57–59
Merchant SS, Prochnik SE, Vallon O, Harris EH, Karpowicz SJ, Witman et al (2007) The Chlamydomonas genome reveals the evolution of key animal and plant functions. Science 318:245–250
Metzger P, Casadevall E (1987) Lycopadiene, a tetraterpenoid hydrocarbon from new strains of the green alga Botryococcus braunii. Tetrahedron Lett 28:3911–3934
Metzger P, Berkaloff C, Casadevall E, Coute A (1985a) Alkadiene-producing and botryococcene-producing races of wild strains of Botryococcus braunii. Phytochemistry 24:2305–2312
Metzger P, Casadevall E, Pouet MJ, Pouet Y (1985b) Structures of some botryococcenes: branched hydrocarbons from the B-race of the green alga Botryococcus braunii. Phytochemistry 24:2995–3002
Metzger P, Templier J, Largeau C, Casadevall E (1986) An n-alkatriene and some n-alkadienes from the A race of the green alga Botryococcus braunii. Phytochemistry 25:1869–1872
Metzger P, David M, Casadevall E (1987) Biosynthesis of triterpenoid hydrocarbons in the B-race of the green alga Botryococcus braunii. Sites of production and nature of the methylating agent. Phytochemistry 26:129–134
Metzger P, Casadevall E, Couté A (1988) Botryococcene distribution in strains of the green alga Botryococcus braunii. Phytochemistry 27:1383–1388
Metzger P, Allard B, Casadevall E, Berkaloff C, Coute A (1990) Structure and chemistry of a new chemical race of Botryococcus braunii. J Phycol 26:258–266
Metzger P, Pouet Y, Bischoff R, Casadevall E (1993) An aliphatic polyaldehyde from Botryococcus braunii (A race). Phytochem 32:875–883
Metzger P, Rager MN, Fosse C (2008) Braunicetals: acetals from condensation of macrocyclic aldehydes and terpene diols in Botryococcus braunii. Phytochem 69:2380–2386
Moldowan JM, Seifert WK (1980) First discovery of botryococcane in petroleum. JCS Chem Comm 19:912–914
Okada S, Murakami M, Yamaguchi K (1995) Hydrocarbon composition of newly isolated strains of the green microalga Botryococcus braunii. J Appl Phycol 7:555–559
Okada S, Devarenne TP, Chappell J (2000) Molecular characterization of squalene synthase from the green microalga Botryococcus braunii, race B. Arch Biochem Biophys 373:307–317
Page RD (1996) TreeView: an application to display phylogenetic trees on personal computers. Comput Appl Biosci 12:357–358
Prochnik SE, Umen J, Nedelcu AM, Hallmann A, Miller SM, Nishii I et al (2010) Genomic analysis of organismal complexity in the multicellular green alga Volvox carteri. Science 329:223–226
Sawayama S, Inoue S, Yokoyama S (1995) Phylogenetic position of Botryococcus braunii (Chlorophyceae) based on small subunit ribosomal RNA sequence data. J Phycol 31:419–420
Senousy HH, Beakes GW, Hack E (2004) Phylogenetic placement of Botryococcus braunii (Trebouxiophyceae) and Botryococcus sudeticus isolate UTEX 2629 (Chlorophyceae). J Phycol 40:412–423
Stasiuk LD (1999) Confocal laser scanning fluorescence microscopy of Botryococcus alginite from boghead oil shale, Boltysk, Ukraine: selective preservation of various micro-algal components. Org Geochem 30:1021–1026
Summons RE, Metzger P, Largeau C, Murray AP, Hope JM (2002) Polymethylsqualanes from Botryococcus braunii in lacustrine sediments and crude oils. Org Geochem 33:99–109
Tamura K, Dudley J, Nei M, Kumar S (2007) MEGA4: Molecular evolutionary genetics analysis (MEGA) software version 4.0. Mol Biol Evol 24:1596–1599
Templier J, Largeau C, Casadevall E (1984) Hydrocarbon formation in the green-alga Botryococcus braunii. 4. Mechanism of non-isoprenoid hydrocarbon biosynthesis in Botryococcus braunii. Phytochemistry 23:1017–1028
Templier J, Largeau C, Casadevall E (1991) Biosynthesis of normal alkatrienes in Botryococcus braunii. Phytochemistry 30:2209–2215
Testa M, Gerbaudo S, Andri E (2001) Botryococcus Colonies in Miocene Sediments in the Western Woodlark Basin, Southwest Pacific (ODP Leg 180). Proc Ocean Drill Program Sci Results 180:1–6
Traverse A (1955) Occurrence of the oil-forming alga Botryococcus in lignites and other Tertirary sediments. Micropaleontology 1:343–348
Weiss TL, Johnston JS, Fujisawa K, Sumimoto K, Okada S, Chappell J, Devarenne TP (2010) Phylogenetic placement, genome size, and GC-content of the liquid hydrocarbon producing green microalga Botryococcus braunii var. Berkeley (Showa) (Chlorophyta). J Phycol 46:634–540
Acknowledgments
We would like to thank Dr. Margaret E. Glasner from the Department of Biochemistry and Biophysics at Texas A&M University for help with the phylogenetic analysis. This work was supported by Texas A&M University Department of Biochemistry & Biophysics start-up funds to T.P.D.
Author information
Authors and Affiliations
Corresponding author
Rights and permissions
About this article
Cite this article
Weiss, T.L., Johnston, J.S., Fujisawa, K. et al. Genome size and phylogenetic analysis of the A and L races of Botryococcus braunii . J Appl Phycol 23, 833–839 (2011). https://doi.org/10.1007/s10811-010-9586-7
Received:
Revised:
Accepted:
Published:
Issue Date:
DOI: https://doi.org/10.1007/s10811-010-9586-7